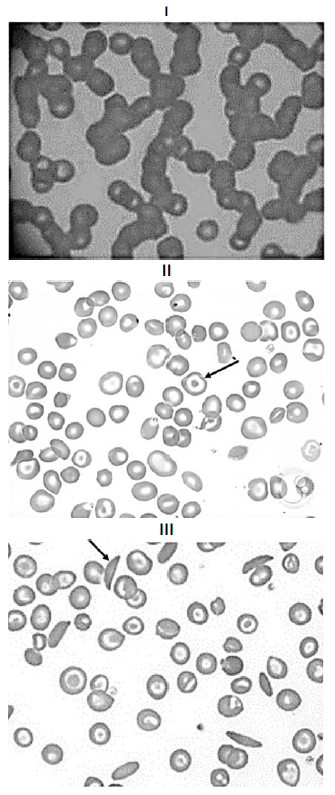
enunciado 323164-1

Um laboratório, durante as análises rotineiras de esfregaço sanguíneo de três amostras (1, 2 e 3), identificou as imagens a seguir.

Com base nessa situação hipotética, assinale a alternativa correta.
Com base nessa situação hipotética, assinale a alternativa correta.